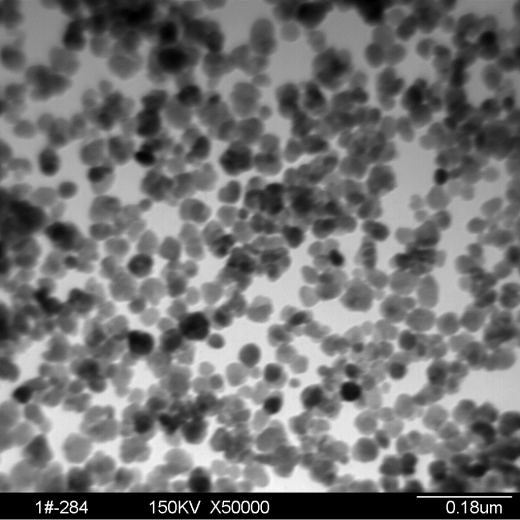

磁性纳米粒子
产品型号:MNP-Weina01
产品全称:磁性纳米粒子
产品规格:客户指定
产品参数:饱和磁化强度80 emu/g
产品尺寸:颗粒尺寸20–40 nm
其他指标:产品应用于磁分离、磁性转染、免疫分析、催化、固相分离、聚合物太阳能电池
在线订购产品详情
磁性纳米粒子产品(MNP-Weina01)主要应用于磁分离、磁性转染、免疫分析、催化、固相分离、聚合物太阳能电池等。

详细请来电咨询或点击在线订购预留信息!
上一篇:没有了!
相关产品
-
产品型号:MNP-Weina01 磁性纳米粒子
-
产品型号:MNP-Weina02 表面富氨基核-壳式结构磁性纳米粒子
-
产品型号:InCl₂-weina01 纳米化合物-三氯化铟
-
产品型号:GaCl3-weina01 纳米化合物-三氯化镓









